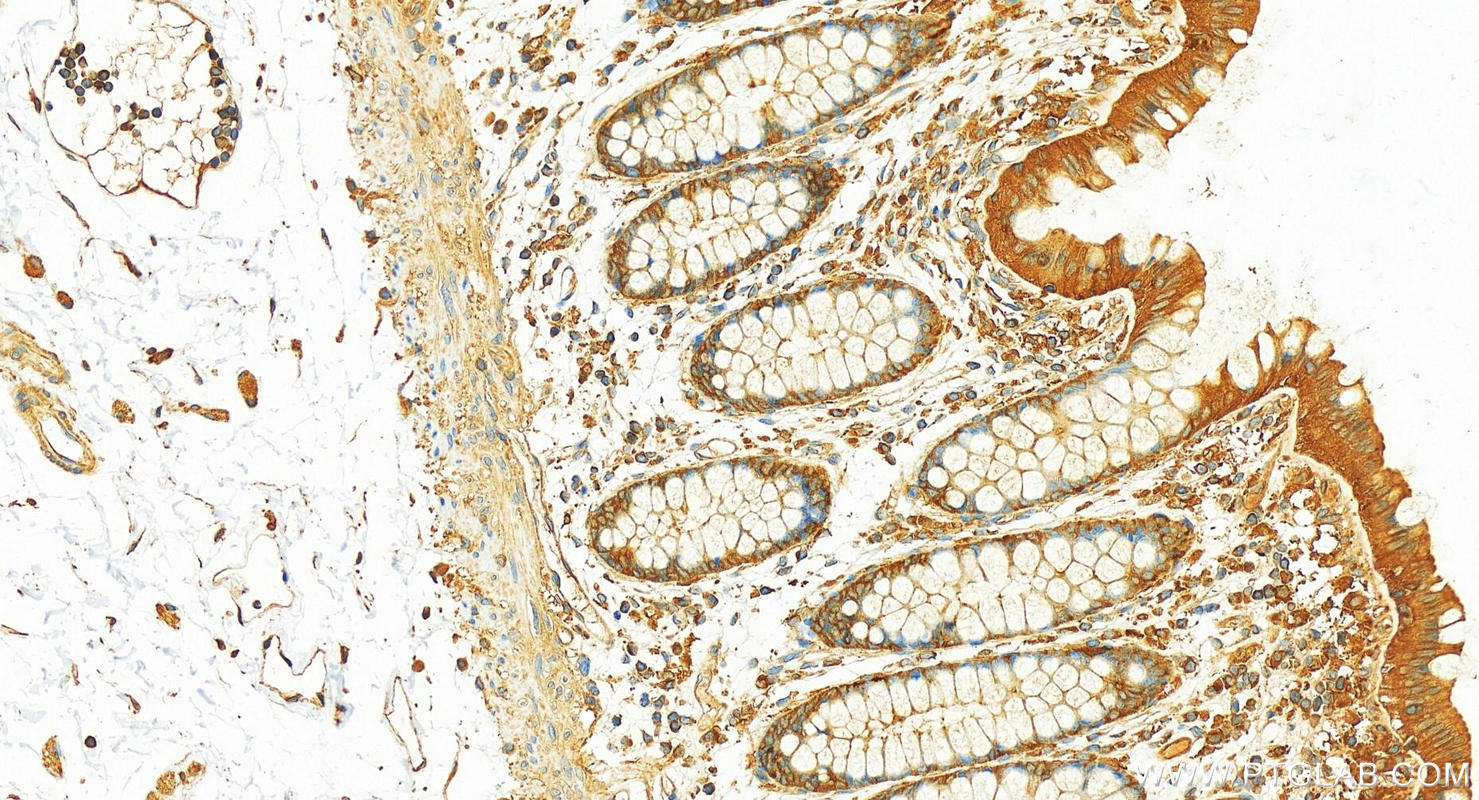

验证数据展示
经过测试的应用
| Positive WB detected in | A431 cells, rat brain tissue, mouse spleen tissue, rat spleen tissue, HeLa cells, mouse brain tissue |
| Positive IHC detected in | human gliomas tissue, human colon tissue, mouse brain tissue Note: suggested antigen retrieval with TE buffer pH 9.0; (*) Alternatively, antigen retrieval may be performed with citrate buffer pH 6.0 |
推荐稀释比
| 应用 | 推荐稀释比 |
|---|---|
| Western Blot (WB) | WB : 1:2000-1:16000 |
| Immunohistochemistry (IHC) | IHC : 1:200-1:1600 |
| It is recommended that this reagent should be titrated in each testing system to obtain optimal results. | |
| Sample-dependent, Check data in validation data gallery. | |
产品信息
10116-1-AP targets GDI2 in WB, IHC, IF, ELISA applications and shows reactivity with human, mouse, rat samples.
| 经测试应用 | WB, IHC, ELISA Application Description |
| 文献引用应用 | WB, IHC, IF |
| 经测试反应性 | human, mouse, rat |
| 文献引用反应性 | human, mouse, monkey, yeast |
| 免疫原 |
CatNo: Ag0170 Product name: Recombinant human GDI2 protein Source: e coli.-derived, PGEX-4T Tag: GST Domain: 1-234 aa of BC005145 Sequence: MNEEYDVIVLGTGLTECILSGIMSVNGKKVLHMDRNPYYGGESASITPLEDLYKRFKIPGSPPESMGRGRDWNVDLIPKFLMANGQLVKMLLYTEVTRYLDFKVTEGSFVYKGGKIYKVPSTEAEALASSLMGLFEKRRFRKFLVYVANFDEKDPRTFEGIDPKKTTMRDVYKKFDLGQDVIDFTGHALALYRTDDYLDQPCYETINRIKLYSESLARYGKSPYLYPLYGLGEL 种属同源性预测 |
| 宿主/亚型 | Rabbit / IgG |
| 抗体类别 | Polyclonal |
| 产品类型 | Antibody |
| 全称 | GDP dissociation inhibitor 2 |
| 别名 | RABGDIB, Rab GDI β, Rab GDI beta, GDP dissociation inhibitor 2, GDI-2 |
| 计算分子量 | 47 kDa |
| 观测分子量 | 46 kDa |
| GenBank蛋白编号 | BC005145 |
| 基因名称 | GDI2 |
| Gene ID (NCBI) | 2665 |
| RRID | AB_2279073 |
| 偶联类型 | Unconjugated |
| 形式 | Liquid |
| 纯化方式 | Antigen affinity purification |
| UNIPROT ID | P50395 |
| 储存缓冲液 | PBS with 0.02% sodium azide and 50% glycerol, pH 7.3. |
| 储存条件 | Store at -20°C. Stable for one year after shipment. Aliquoting is unnecessary for -20oC storage. |
背景介绍
GDP dissociation inhibitors (GDIs) are proteins that regulate the GDP-GTP exchange reaction of members of the rab family, GDIs can bind and release GDP-bound Rab proteins from membranes. Two GDI proteins towards different Rab proteins have been identified. GDI1 interacts with almost all of the Rab proteins, while GDI2 interacts with Rabll but not Rab3A. GDI2 distributes ubiquitously, displaying a membrane bound location in perinuclear regions of cells. GDI-2 was thought to be involved in cellular response to insulin. It electrophoreses as a 46kd protein in SDS-PAGE. (PMID: 7929030; PMID: 19570034). This antibody can bind both GDIs for the close sequences.
实验方案
| Product Specific Protocols | |
|---|---|
| IHC protocol for GDI2 antibody 10116-1-AP | Download protocol |
| WB protocol for GDI2 antibody 10116-1-AP | Download protocol |
| Standard Protocols | |
|---|---|
| Click here to view our Standard Protocols |
发表文章
| Species | Application | Title |
|---|---|---|
Proc Natl Acad Sci U S A Structural mechanism of host Rab1 activation by the bifunctional Legionella type IV effector SidM/DrrA. | ||
Curr Biol Rab34 GTPase mediates ciliary membrane formation in the intracellular ciliogenesis pathway. | ||
Hum Mol Genet Disease mutations in Rab7 result in unregulated nucleotide exchange and inappropriate activation. | ||
Mol Cell Proteomics Differential proteomics analysis of synaptic proteins identifies potential cellular targets and protein mediators of synaptic neuroprotection conferred by the slow Wallerian degeneration (Wlds) gene. |